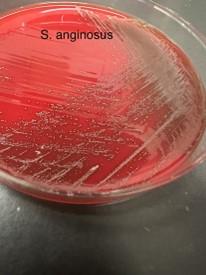

口腔是身體健康的重要入口,同時也是微生物的樂園。然而,我們常常忽略了口中微生物的威力。它們不僅影響著口腔健康,還可能對整體健康產生深遠的影響,甚至與癌症有關。口腔中的微生物包括細菌、病毒和真菌,共同構築了一個微觀世界。這些微生物在口腔中和諧共存,但一旦失去平衡,就可能引發各種健康問題。
口腔微生物可能與許多疾病有關?
近年的研究顯示,口腔微生物可能與多種慢性疾病有關。例如,口腔中的細菌和病毒可以引發口腔疾病,如牙周病,進而導致口腔組織的炎症。這種炎症反應可能通過血液循環進入全身,對心血管系統產生負面影響,增加心臟病和中風的風險。
此外,口腔中的微生物也可能影響糖尿病的發展和控制。牙周病和牙齒問題的存在可能使糖尿病更難控制,反之亦然,糖尿病本身也可能加重口腔健康問題。同時,口腔微生物也可能進入呼吸道,導致呼吸系統感染和其他問題。
口腔微生物與癌症有何關聯?
口腔微生物與癌症的關聯是一個相對新的研究領域,但近年來越來越受到關注。最近有研究發現,某些口腔細菌可能與胃癌風險增加有關。感染咽峽炎鏈球菌(Streptococcus anginosus)的人可能更容易患上胃癌,因為這些細菌能在胃部引發炎症反應,進而促進腫瘤的生長。
除了與胃癌的關聯外,還有一些研究表明口腔微生物可能與其他癌症有關。例如,有研究顯示口腔細菌可能與口腔癌和喉癌有關聯。不過,這些研究結果還需要更多的深入研究來確定口腔微生物和癌症之間的確切關係,以及它們可能如何影響癌症的發展和進展。

小小問答知識:
- 問:感染咽峽炎鏈球菌有哪些徵狀?
答:感染咽峽炎鏈球菌可能出現口腔問題,如口腔疼痛或潰瘍,同時也可能引起胃部不適和消化問題。全身性症狀如發燒、乏力也可能出現。長期感染可能增加胃癌風險。如果出現這些徵狀,應及時就醫尋求專業意見。
- 問:哪些口腔微生物常見且可能影響身體健康?
答:一些常見的口腔微生物可能對身體健康產生影響,包括幽門螺旋桿菌、咽峽炎鏈球菌、牙周病菌、益生菌(如嗜酸乳桿菌和酪酸乳桿菌)、以及白色念珠菌。這些微生物可能通過引發炎症反應等機制影響身體健康。因此,保持口腔健康至關重要。
- 問:口腔微生物失衡可能導致哪些健康問題?
答:口腔微生物失衡可能導致牙齒蛀牙、牙周疾病(如牙齦炎和牙周病)、口腔感染(如口腔鵝口瘡)、口氣惡臭等健康問題。此外,口腔微生物失衡還可能與全身性疾病(如心臟病、糖尿病)和癌症等疾病的發生和發展有關。
- 問:如何確保口腔微生物的平衡?
答:除了定期刷牙、使用牙線和接受口腔檢查外,適當的飲食也是維持口腔微生物平衡的關鍵。減少糖分和澱粉質的攝取,增加蔬菜和水果的攝入有助於預防微生物失衡。同時,戒煙和限制酒精飲用也對口腔健康至關重要。
- 問:口腔微生物發展成全身性疾病或胃癌會經過什麼階段?
答:口腔微生物發展成全身性疾病或胃癌通常經歷幾個階段:初始感染,引發炎症,進展為慢性問題,影響全身健康,最終可能促進癌症形成。
這些研究結果為我們提供了一個全新的角度,重新思考口腔健康對整體健康的影響。在日常生活中,口腔健康常常被忽視,但其對整體健康的影響卻是深遠的。透過適當的口腔護理,如定期刷牙、使用牙線、定期口腔檢查,我們能有效維持口腔微生物的平衡,減少其對健康的負面影響。同時,健康的飲食和生活方式也是保持口腔微生物平衡的重要因素。因此,讓我們珍惜口腔健康,不僅為了獲得清新的氣息和燦爛的笑容,更是為了我們身體的整體健康。
















